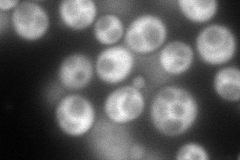
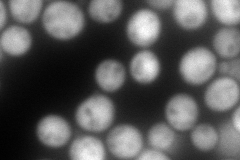
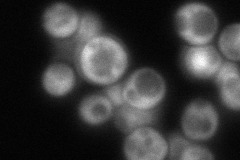

View description
eIF3g subunit of the core complex of translation initiation factor 3 (eIF3), which is essential for translation
Localization:
Intensity:
Fold change:
Significance:
-
C’ GFP library in SD

cytosol167.32 -
N' NOP1pr-GFP in SD
cytosol236.927 -
N' TEF2pr-mCherry in SD
cytosol292.833 -
N' NATIVEpr-GFP in SD
cytosol137.396 -
N' TEF2pr-VC and Cyto-VN in SD

cytosol68.3485 -
C’ GFP library in SD+DTT

cytosol107.460.64No -
C’ GFP library in SD+H2O2

cytosol136.740.81No -
C’ GFP library in Starvation Media

cytosol97.020.57Yes -
C’ GFP library on the background of Pup2-DaMP

cytosol -
C’ GFP library on the background of CCT mutant

cytosol16.3980.0980025Yes
